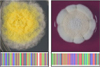

|
발암 유전자 MCL1을 표적으로 삼는 방법 ...
|
2012/04/24 |
|
발암 유전자 MCL1을 표적으로 삼는 방법 || 인류 진화 성공은 ‘고기’ 덕분이다? || 뇌에서 새 성체줄기세포 발견 || 곰팡이의 습격, 지구 재앙 부르나 || 신체일부에 기계 이식 '바이오닉스' 뜬다 - 손상 조직 인공물로 대체하는 기술 || 어린이 지적...
|
|

|
'꽃 피우는 단백질' 이동 경로 찾았다. - FT, FTIP1과 결합...
|
2012/04/20 |
|
'꽃 피우는 단백질' 이동 경로 찾았다. - FT, FTIP1과 결합 || 日 연구진, 뼈건강 단백질 발견 - 세마포린3A || 암, 정신 지체 등 각종 유전질환 유발 원인 밝힐 단서 찾아... || 신약 개발의 새로운 방향을 제시하다...서울대학교 박승범 교...
|
|

|
곰팡이, 신분증으로 식별 가능-'리보솜 DNA ITS' 선발...
|
2012/04/20 |
|
곰팡이, 신분증으로 식별 가능-'리보솜 DNA ITS' 선발 || 표적단백질 명확히 선별 확인…신약개발 새 장 열어 || 세포 분열과 유전질환의 연계성 규명 새 전기 마련 || 생쥐 간세포에서 역분화줄기세포 유도후 간세포로 분화 성공 || 호주 연구팀, 새로...
|
|

|
인간의 혈장 칼리크레인을 억제하는 두고리형 펩타이드...
|
2012/04/18 |
|
인간의 혈장 칼리크레인을 억제하는 두고리형 펩타이드 || "치매환자 꾸준히 증가…2050년 200만명 넘어" - 국가치매관리위원회 구성 등 인프라 구축 || 모낭 줄기세포 이식으로 모발재생 - 무모증 쥐서 발모 확인, 새로운 증모법 기대 || 암세포 성장에 대...
|
|
|
서울대병원,'배아'서 '간엽줄기세포' 유도 新기술 개발 ...
|
2012/04/17 |
|
서울대병원,'배아'서 '간엽줄기세포' 유도 新기술 개발 || 시각장애인 과학자들에게 그래픽 정보를 제공 || 종자크기, 모계 유래 작은 RNAs에 의해 결정 || 인간 기억력과 두뇌 크기 연관 유전자 발견 || 연구자임상도 트렌드 반영 - 지방줄기세포 이용...
|
|
|
